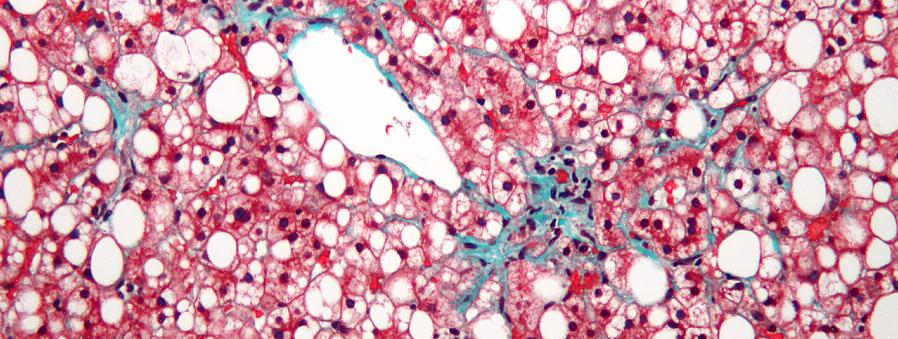

פציעות וצלקות שיכולות להגביל את יכולות האימון שלך
פציעות וצלקות מפצעים או ניתוחים עלולים להפריע לאימונים שלך. חשוב מאוד להמתין עד שהם ירפאו כמעט לחלוטין ובמידת הצורך לשנות את שגרת האימון בהתאם. למד עוד על טיפול בפציעות וצלקות במאמר זה.
אתה עשוי לאהוב: הפציעות השכיחות ביותר של השרוול המסובב
פציעות וצלקות: מה שאתה צריך לדעת
לתאי העור תפקידים רבים. תפקיד אחד הוא לתקן רקמות שנפגעו מסיבות שונות. הדרמיס הוא אחד האיברים הגדולים ביותר בגוף האדם. מכיוון שהעור שלך חשוף לעתים קרובות לסביבה, הוא אחראי על 'החלפת' מידע בין הפנים והחוץ.
כאשר מתרחשות פציעות וצלקות, אתה עלול להיתקל בבעיות יציבה, תחושתיות או מוטוריות מסוימות. הפרעות אלו יכולות אפילו להתפשט ולהשפיע על אזורים אחרים בגוף.
לדוגמה, אם יש לך חתך בכף היד, כנראה שזה כואב להחזיק חפץ כמו משקולת. כתוצאה מכך, לא תוכל לסגור את האצבעות סביבו כראוי.
צלקות יכולות להופיע לאחר ניתוח, חתכים, טראומות או כוויות. התהליך שעובר העור כדי לרפא את הפצעים הללו הוא כנראה מורכב יותר ממה שאתה חושב. ראשית, הדימום נושא אלמנטים כמו טסיות דם, גליקופרוטאין או פיברין ומנסה לכיווץ את כלי הדם שלך.
מאותו רגע, הגוף פועל ללא לאות כדי לרפא את הפצע הזה. מעל לכל, הגוף שלך מנסה למנוע מחיידקים להיכנס. השלב האחרון של הריפוי ידוע גם בשם שיפוץ ויכול לקחת ימים, שבועות או אפילו חודשים. הכל תלוי בגודל ובמאפייני הפצע.
כאשר פציעות וצלקות מהוות בעיה
אם הדרמיס והפאשיה (השכבה הפנימית של העור, עם קולטני כאב) מושפעים מפציעות עמוקות יותר וצלקות, זה יכול לשנות את המבנים העדינים שלהם. כתוצאה מכך, זה יכול להוביל פחות אינטראקציה פנימית-חיצונית.
סיבי Fascia הם פחות אלסטיים במהלך תהליך הריפוי. לחץ ומתח הם הבעיות העיקריות כאשר אתה מנסה להתאמן, להרים חפץ או להשתמש בכוח רב.
בנוסף לסיכון שהפצע ייפתח או יידבק, הכאב יכול גם להחמיר. עם זה, יש גם שינויים בהרגלים או התנועות שלנו.
כמובן, אם יש לך פציעה בכף הרגל, סביר להניח שתעביר את משקל הגוף לרגל השנייה שלך. כתוצאה מכך, אתה עלול לגרום לכאב בברך או לעבוד יתר על המידה בירך, בין יתר בעיות.
דוגמה נוספת היא אם יש לך חתך ביד אחת, ובמקום להשתמש בצד הזה כדי להרים משקל, תעשה זאת ביד הנגדית. שינויים ביציבה או באימון יכולים להוביל לבעיות רבות. זה יכול להשפיע לא רק על שגרת האימון שלך אלא גם על חיי היום יום שלך.
כיצד למנוע ולטפל בפציעות וצלקות
כצעד ראשון, עליך להיות זהיר מאוד כשאתה מתאמן: נסה כמיטב יכולתך להימנע מחתכים וחבלות, שלפוחיות או שפשופים שיכולים להחמיר את האימון שלך או לא לאפשר לך להתאמן בהתאם.
בהתאם לסוג הפעילות הגופנית שאתה עושה, עליך להגן על העור שלך ואזורים אחרים המועדים ביותר לפציעה. לדוגמה, כפות הידיים שלך עלולות להיפגע בקלות אם אתה מרים משקולות. כמו כן, העקבים שלך עלולים לסבול אם אתה רץ והמפשעה שלך אם אתה רוכב על אופניים.
במובן זה, תחבושות בד הן דרך מצוינת למנוע פצעים אך לא הדרך היחידה. אתה יכול גם להרטיב את הדרמיס עם קרמים ואפילו להשתמש בטלק או קמח כדי לסייע במניעת זיעה וחיכוך.
אולי תאהב: הדרך הנכונה להתאמן עם בעיות גב
טיפ חשוב נוסף: אל תלבש בגדים או נעליים חדשות במהלך אימון אינטנסיבי או תחרות. תחילה עליך לוודא שהגוף מסתגל למרכיבים אלו.
בנוסף, חשוב לפרוץ את הבגדים והנעליים החדשים שלך כדי למנוע או להפחית את ההשלכות השליליות של החיכוך או הלחץ הראשוני.
כיצד לפעול בבעיות עור אלו
במקרה שהתרחשו פציעות וצלקות עקב פעילות גופנית או מצב חיצוני אחר, חיוני להתייעץ עם מומחה. איש מקצוע רפואי זה יוכל לומר לך מתי בטוח לחדש את הפעילות הגופנית. בנוסף, הם יטפלו בפציעות ובצלקות שלך וילמדו אותך גם איך לטפל בהן.
כיסוי פצע בתחבושת או גזה יספיק ככל הנראה כדי למנוע מגע עם חיידקים. עם זאת, בכל הנוגע לרמות הכאב ואי הנוחות, ייתכן שתיאלצו להמתין עוד קצת כדי להרגיש במצב מושלם ולחזור להתאמן.
אם הפצע נובע מניתוח כירורגי, אתה לא יכול פשוט לחדש את כל הפעילויות לאחר הסרת התפרים. יש תהליך שלאחר מכן שיש לדבוק בו כדי שהפצעים לא ייפתחו ויצרו סיבוכים נוספים. כתוצאה מכך, עדיף להמתין זמן מה ולהימנע מניתוח חירום.